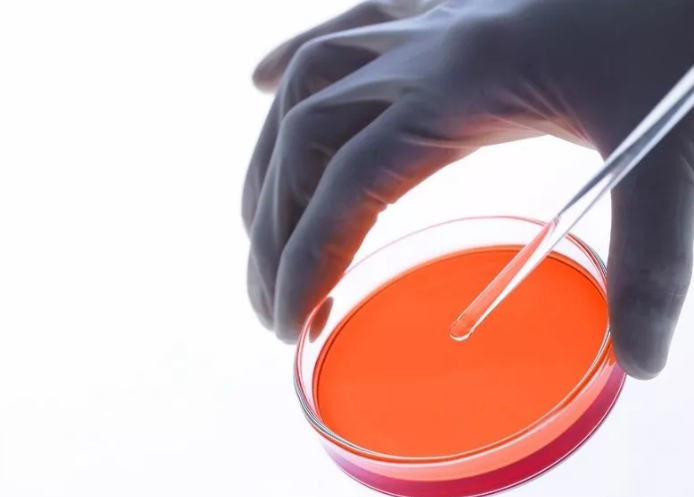
QQ图片20190509113656.png

做俄罗斯试管婴儿需要多长时间可以回国����?这也是一些较为关心的问题��,随着俄罗斯试管婴儿技术在国内不断的宣传���,让大多数难孕育对俄罗斯试管婴儿有了详细的了解�,促使俄罗斯试管婴儿成为了大多数难孕育的生育首选�。但是做俄罗斯试管婴儿需要多长时间,这就需要根据顾客的情况来确定的�����。
我们可以根据做俄罗斯试管婴儿的一般流程来计算做俄罗斯试管婴儿需要多长时间
第一步�����,提交报告:
需提供近三个月内夫妻双方的身体检查报告�,以便准确评估做俄罗斯试管婴儿的成功率。因为近期的体检报告可以检测出体内是否存在其他病症��,以免到达俄罗斯之后检查出问题�����,目的是较大限度节省在俄时间和费用�。
第二步,专家视频会诊:
在国内����,预约俄罗斯试管婴儿专家的医生视频会诊。届时����,医生会根据病例病史及检查结果。同时��,俄罗斯试管婴儿专家还会再列出一张检查表单�����,让在赴俄之前检查一遍����。
第三步��,确定试管婴儿周期:
与专家会诊结束���,根据专家开具的检查列表到当地的医院自行检查,检查结果出来后有专人会将检查结果翻译出来发给俄罗斯试管婴儿专家�����,专家通过较新检查结果为专门定制俄罗斯试管婴儿周期和方案���。
注:
女性:激素六项(例假第2或第3天����、抽血检查�,需空腹)、检查AMH(抗缪勒氏管激素����,无时间限制)、阴超(例假第2或第3天����,检查左右卵巢基础卵泡数量�、子宫内膜厚度、子宫和双侧卵巢形态、大小����、有无子宫肌瘤和卵巢囊肿);
男性:精液常规检查(禁欲3-5天后检查)���。
第四步�����,前往俄罗斯:
提前订好出行时间�,预订机票出行��。
第五步���,促排卵:
俄罗斯试管婴儿专家介绍�,女性一生仅排出大概400个成熟卵子�����,正常情况下��,女性每个月会排出一到两颗卵子��,但能够达到成熟状态的却只有一个,这是因为女性身体机能的自我选择���,会选择一个发展态势良好的来重点培育�。
但是����,一个卵子对于一个俄罗斯试管婴儿周期来说,数量实在太少�����,为保证俄罗斯试管婴儿手术的成功率以及胎儿的健康性�����,俄罗斯试管婴儿专家在取卵前都要进行促排卵的准备�����。
俄罗斯试管婴儿专家会给注射促排卵针���,保证在一个月经周期内排出多个卵子��,一般来说����,促排卵针会选择在月经周期的第2天来注射����,连续用药7-9天。
与此同时����,俄罗斯试管婴儿专家会时刻关注卵泡的发育情况,为下一步的取卵做准备�����。
第六步����,取精取卵:
男性自取一定的精液交给医生。
当取卵者体内的卵子发育的指定程度后����,医生会为取卵者全麻进行取卵手术。
第七步�����,体外受精,囊胚培养
取卵后4~5小时�,将处理后的精子与卵子放在同一个培养皿中,共同培养18小时后�,可在显微镜下观察受精情况。
针对有遗传疾病或者卵子�、精子质量不好的胚胎,俄罗斯试管婴儿专家建议可以选择俄罗斯第三代试管婴儿技术�����,通过PGD/PGS基因染色体筛查技术��,筛查出遗传疾病的囊胚�,从而保证移植健康的囊胚。
第八步����,囊胚移植
受精卵在体外培养48~72小时可发育到8~16细胞期胚胎。然后再将第三天的鲜胚继续培养到第五天甚至第六天或更多���,胚胎会成长为有囊胚腔的细胞团����,这就叫囊胚。俄罗斯试管婴儿专家解释�����,囊胚的培养与年龄�、曾经怀孕与否及胚胎的质量等多种因素有关。
对囊胚的基因或染色体疾病筛查��,生宝宝�����,并挑选健康的胚胎完成移植�。
第九步�����,确定怀孕回国
囊胚移植后进行黄体酮的补充����,囊胚移植成功后的第12天抽血验孕,确认怀孕后就可以开开心心地回国�����,安安心心地养胎����。

